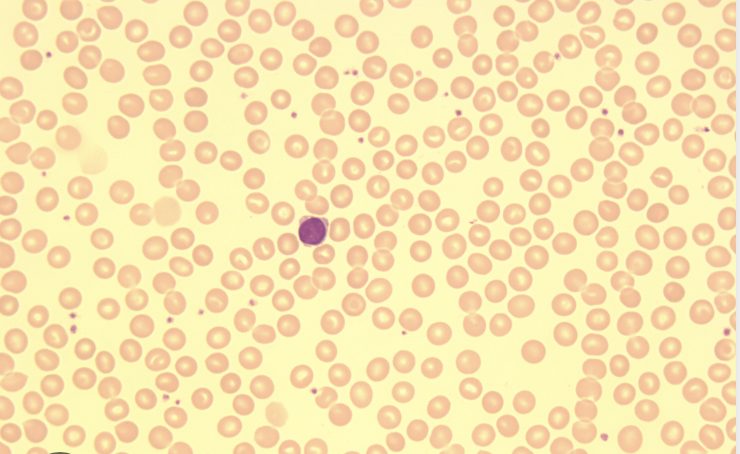
<p>What are normocytes?</p>
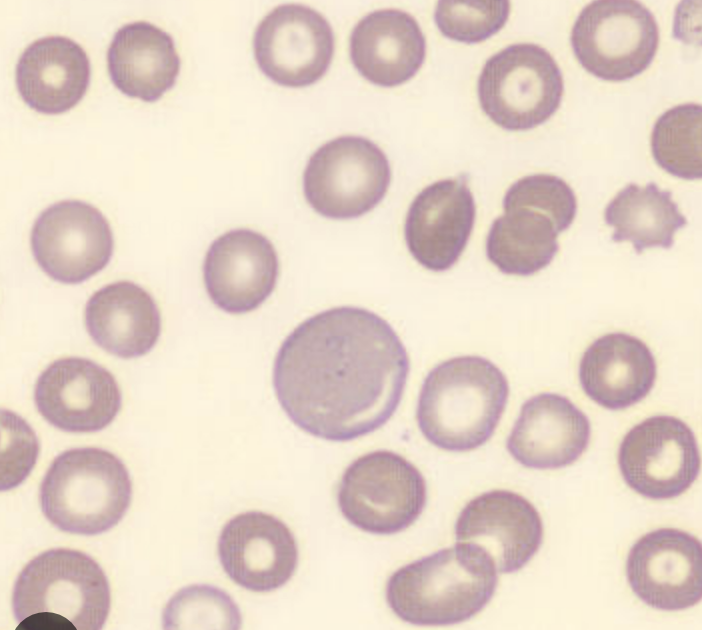
<p>What are macrocytes?</p>
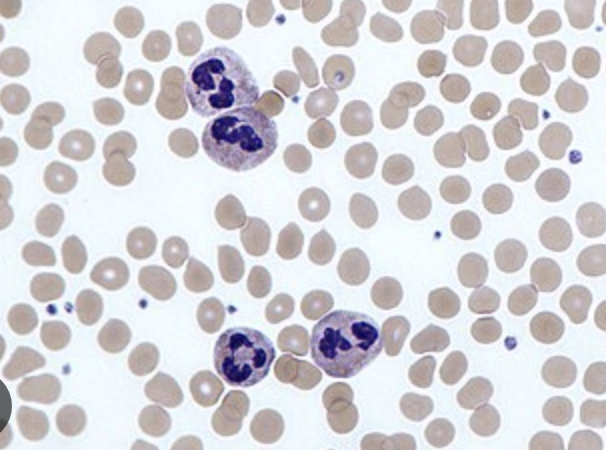
<p>Neutrophils increase in what conditions?</p>
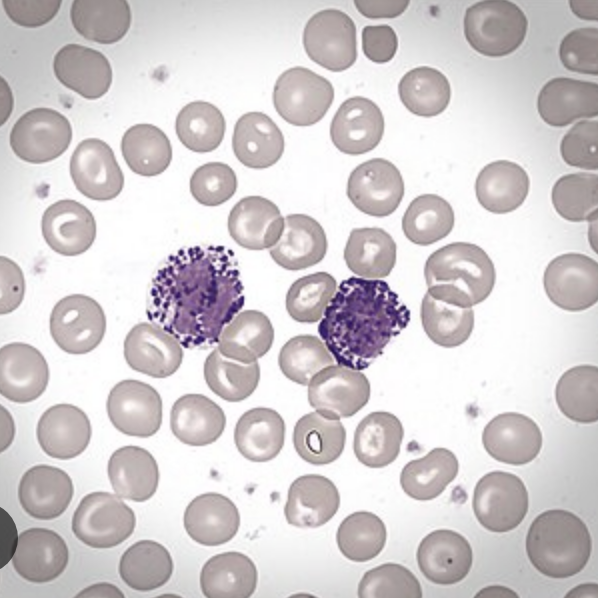
<p>Basophils increase in what conditions?</p>
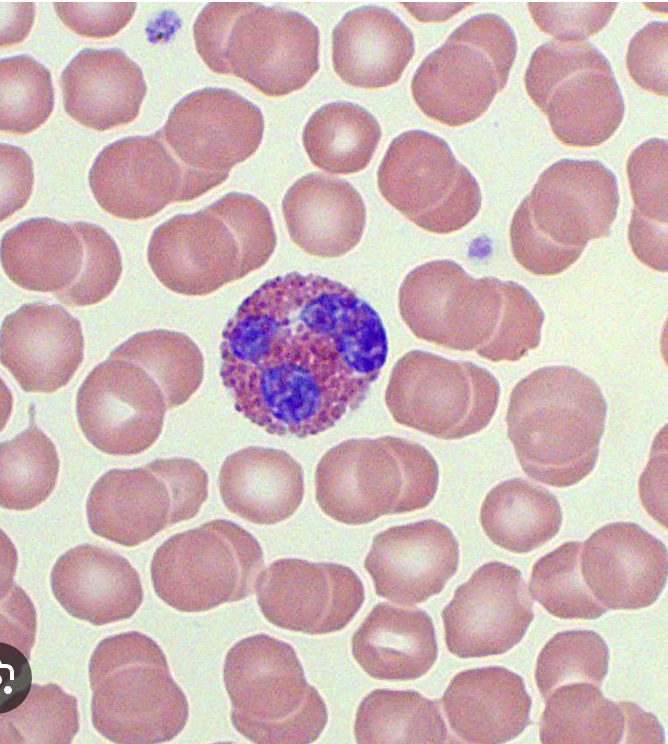
<p>Eosinophils increase in what conditions?</p>
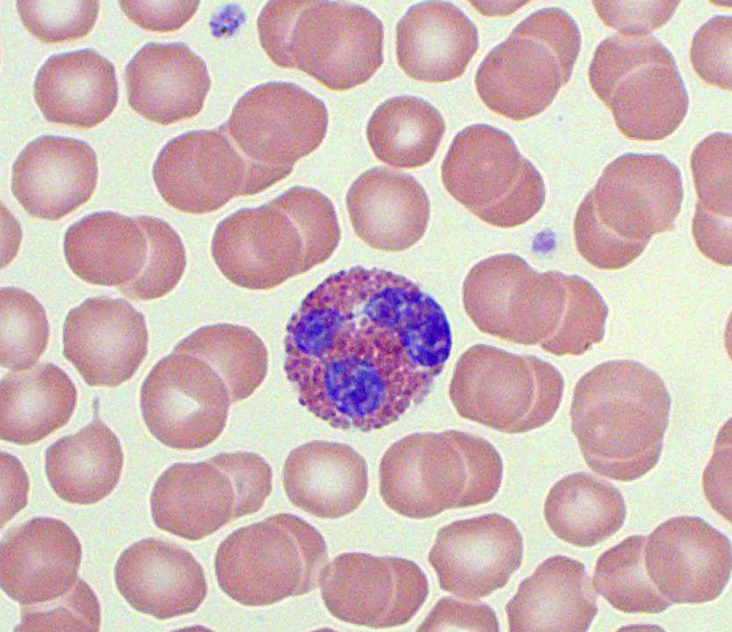
<p>Eosinophils decrease in what conditions?</p>
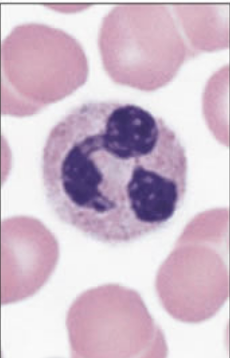
<p>How to identify neutrophils?</p>
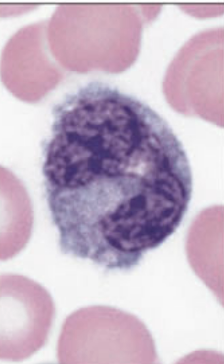
<p>How to identify monocytes?</p>

1/39
Looks like no tags are added yet.
Name | Mastery | Learn | Test | Matching | Spaced | Call with Kai |
|---|
No analytics yet
Send a link to your students to track their progress

What is blood typing used for?
To determine a person’s blood type based on antigens present on red blood cells.
What are antigens in blood typing?
Proteins on the surface of red blood cells (A and/or B antigens).

What does agglutination (clumping) indicate?
Presence of the corresponding antigen.
If blood clumps with Anti-A serum, what type?
Type A
If blood clumps with Anti-B serum?
Type B
If blood clumps with both Anti-A and Anti-B?
Type AB
If no clumping occurs?
Type O
What antibodies are in Type A blood?
Anti-B antibodies
What antibodies are in Type B blood?
Anti-A antibodies
What antibodies are in Type AB blood?
None
What antibodies are in Type O blood?
Anti-A and Anti-B

What does the Talquist method test for?
Hemoglobin concentration in blood.
How does the Talquist method work?
Blood color is compared to a standardized color chart.
What does a lighter color indicate?
Lower hemoglobin (possible anemia)

What is hematocrit?
Percentage of red blood cells in total blood volume.
How is hematocrit measured?
By spinning blood in a capillary tube and reading RBC proportion.
What are the layers after centrifugation?
Plasma (top), buffy coat (WBCs/platelets), RBCs (bottom)
Why do males have higher hematocrit?
Testosterone increases RBC production.
How do you read hematocrit?
Measure RBC layer ÷ total blood column × 100

What are normocytes?
Normal-sized RBCs (~86.4 μm³)

What are microcytes?
Small RBCs (low MCV)
What conditions cause microcytes?
Iron deficiency anemia, thalassemia
What are macrocytes?
Large RBCs (high MCV)
What conditions cause macrocytes?
Pernicious anemia, folic acid deficiency, RBC regeneration
What is anemia?
A condition with reduced oxygen-carrying capacity of blood (low RBCs or hemoglobin).
What is the function of hemoglobin?
To transport oxygen in red blood cells.

What are leukocytes?
White blood cells that fight infection.

Which leukocytes are granulocytes?
Neutrophils, eosinophils, basophils

Which are agranulocytes?
Lymphocytes, monocytes
Neutrophils increase in what conditions?
Acute bacterial infections, appendicitis, strenuous exercise
Basophils increase in what conditions?
Hemolytic anemia, chicken pox
Eosinophils increase in what conditions?
Asthma, hay fever, scarlet fever
Eosinophils decrease in what conditions?
Stress

Lymphocytes increase in what conditions?
Mumps, measles, whooping cough

Monocytes increase in what conditions?
Infectious mononucleosis, malaria
How to identify neutrophils?
Multi-lobed nucleus, fine granules

How to identify eosinophils?
Bilobed nucleus, red/orange granules

How to identify basophils?
Dark purple granules, nucleus hard to see

How to identify lymphocytes?
Large nucleus, thin cytoplasm
How to identify monocytes?
Kidney-shaped nucleus, largest WBC